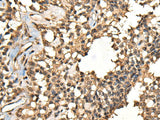
CASK Polyclonal Antibody Reactivity Human

CASK Polyclonal Antibody Reactivity Human
SKU: E-AB-52518-200
CASK Polyclonal Antibody Reactivity Human
| SKU # | E-AB-52518 |
| Reactivity | Human, Mouse, Rat |
| Host | Rabbit |
| Applications | IHC |
Product Details
| Isotype | IgG |
| Host | Rabbit |
| Reactivity | Human, Mouse, Rat |
| Applications | IHC |
| Clonality | Polyclonal |
| Immunogen | Fusion protein of human CASK |
| Abbre | CASK |
| Synonyms | CAGH39, Caki, Calcium/calmodulin dependent serine protein kinase , Calcium/calmodulin dependent serine protein kinase (MAGUK family), Calcium/calmodulin dependent serine protein kinase membrane associated guanylate kinase, Calcium/calmodulin-dependent serine p |
| Swissprot | |
| Cellular Localization | Nucleus. Cytoplasm. Cell membrane. |
| Concentration | 0.9 mg/mL |
| Buffer | Phosphate buffered solution, pH 7.4, containing 0.05% stabilizer and 50% glycerol. |
| Purification Method | Antigen affinity purification |
| Research Areas | Neuroscience, Signal transduction |
| Conjugation | Unconjugated |
| Storage | Store at -20°C Valid for 12 months. Avoid freeze / thaw cycles. |
| Shipping | The product is shipped with ice pack, upon receipt, store it immediately at the temperature recommended. |
Related Reagents
| Applications | Recommended Dilution |
| IHC | 1:50-1:300 |
Background
This gene encodes a calcium/calmodulin-dependent serine protein kinase. The encoded protein is a MAGUK (membrane-associated guanylate kinase) protein family member. These proteins are scaffold proteins and the encoded protein is located at synapses in the brain. Mutations in this gene are associated with FG syndrome 4, mental retardation and microcephaly with pontine and cerebellar hypoplasia, and a form of X-linked mental retardation. Multiple transcript variants encoding different isoforms have been found for this gene.